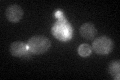
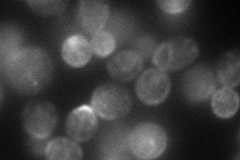

View description
Transmembrane osmosensor, participates in activation of both the Cdc42p- and MAP kinase-dependent filamentous growth pathway and the high-osmolarity glycerol response pathway
Localization:
Intensity:
Fold change:
Significance:
-
C’ GFP library in SD
bud neckN/A -
N' NOP1pr-GFP in SD
cell periphery,ER,bud neck104.652 -
N' TEF2pr-mCherry in SD

cell periphery,ER,bud neck155.694 -
N' NATIVEpr-GFP in SD

bud neck22.6819 -
N' TEF2pr-VC and Cyto-VN in SD

punctate,bud neck31.9144 -
C’ GFP library in SD+DTT

bud neckN/AN/ANo -
C’ GFP library in SD+H2O2

bud neckN/AN/ANo -
C’ GFP library in Starvation Media

bud neck19.130.7Yes -
C’ GFP library on the background of Pup2-DaMP

bud neck -
C’ GFP library on the background of CCT mutant

bud neck22.6420.839186No
